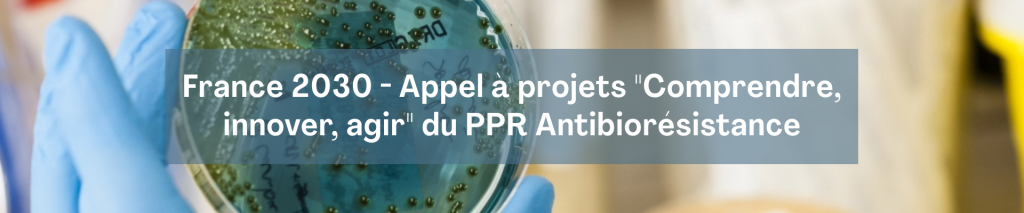

Doté par l’État de 40M€ sur 10 ans dans le cadre du troisième programme d’investissement d’avenir (PIA3) intégré dans le plan France 2030, le programme prioritaire de recherche (PPR) sur l’antibiorésistance a permis de financer de multiples projets de recherche.
En 2020, le premier appel à projets “Comprendre, innover, agir” était lancé avec un budget de 25M€. Ce dernier a permis de soutenir 11 projets ambitieux, structurants et favorisant l’interdisciplinarité en s’inscrivant dans une approche “une seule santé” (“One Health”).
Détails de l’appel à projets 2026
En 2026, le PPR Antibiorésistance lance un second appel à projets “Comprendre, innover, agir” doté de 2M€. Il vise à financer des consortia proposant des projets de 4 ans pour des montants de 600k€ à 750k€ autour de 4 grands challenges :
Challenge 1) Dynamiques et contrôle de l’émergence, de la transmission et de la dissémination de l’antibiorésistance
Challenge 2) Optimisation de l’usage des antibiotiques en médecines humaine et vétérinaire
Challenge 3) Déterminants individuels, ethnologiques et sociologiques, économiques, politiques et culturels de l’antibiorésistance
Challenge 4) Innovation thérapeutique
Calendrier
- Ouverture : 08/01/2026 à 08:00 CET
- Limite de dépôt des projets : 14/04/2026 à 11:00 CET